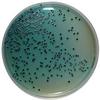
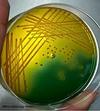
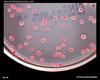
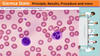

Microbial laboratory diagnostics Flashcards
(31 cards)
What is acid fast staining used to identify? What are some of the defining features of this procedure?
TB (mycobacterium)
- Primary stain = lipid soluble
- Steam heating enhances penetration of stain
- HCl/alcohol destains non-acid fast microogranisms
- Methylene blue counterstains non-acid fast mircoorgansims

The Capsule stain is used to detect the presence of extracellular capsules. What is the positive indication of this stain?
K. Pneumoniae
- smik milk medium
- congo red or crystal violet
- Medium (background) will stain as well as bacterial cells
- The capsule will not stain leaving a halo around the bacterial cells

What is the general purpose desciption of culture media?
Designed to grow most microorganisms
Do not contain growth inhibitors
Example: Blood agar medium
What is the definition of selective media?
Favor the growth of distinct groups of microorganisms while inhibiting others
Examples: PAE agar contains phenylethyl alcohol which inhibit gram-negative microorganisms
What is the definition of differential media?
Distinguishes microogranisms having defined metabolic activity over others that lack it
Example: Simmons citrate agar
What is an example of selective, differential media?
Mannitol salt agar
- selective: 7.5% salt inhibits all but stapholococci organisms
- differential: only s. aureus ferments mannitol
What is one of the way to test specifically for gram positive bacteria?
Phenylethyl alcohol agar with blood (PEAB)
Supports gram(+)
Inhibits (-)
What is the purpose of the chocolate agar medium?
H. Influenzae and N. meninigitidis
RBCs lysed by slow heating “chocolate)
–>Release 2 growth factors: X and V
Fastidious microorganisms (^^) require X and V factors
What is one of the ways to test specifically for Gram (-) bacteria?
“Mac”(Conkey) Agar Medium
E.COLI
Selects for gram (-) bacteria
Contains bile salts which inhibit gram (+) bacteria
-Bc gram (-) bacteria ferment lactose the neutral red medium will turn dark pink/red

In addition to the Mac agar, what other medium selects for gram negative?
EMB Methylene blue Agar
- Methylene blue and eosin inhibit gram (+) and favor gram (-)
- Also utilizes lacotse medium to identify lactose fermenters (e.coli)

What is the test one would use in order to identify Enterobacteriaceae such as Salmonella and Shigella?
Hektoen Enteric Agar
High conc. of bile salts inhibit gram(+) and some gram(-) except shigella and salmonella
-Can distinguis salmonella bc contains thiosulfate which salmonella reduces to hydrogen sulfide (black precipitate)
What is the Agar Medium which test for Bordetella pertusis (whooping cough)?
Bordet-Gengou (BG) Agar
-Red
Regan-Lowe Agar
-Black

What is type of agar medium used to test for Legionella sp.?
Buffered charcoal yeast extract agar (BCYE)

What is the agar medium used to test for Vibrio sp.?
TCBS Agar Medium
-causitive agent for cholera, diarrhea, food poisoning
What type of agar medium is used to test for Yersinia sp?
Cefsulodin-Irgasan-Novobiocin Agar
- inhibits both gram (+) and gram (-)
- positive = red-pigemented bullseye
What is the biochemical test used to distinguis between the two gram(+) cocci, staphylococcus and streptococcus?
Catalase test: catalase enzyme breaks down hydrogen peroxide into water and oxygen. Bacteria with catalase enzyme (staphyloccocus) will bubble [+] when hydrogen peroxide is poured on them whereas bacteria without the catalase enzyme (sterptoccocus) will not bubble [-]

What is the coagulase test used for?
Once it is determined that the bacteria is straphyloccocus, this test measures the ability to convert fibrinogen to fibrin (clot) causing agglutination of microorganisms
–>If clot is found, it means that it must be Staphyloccocus Aureus

What is the Oxidase test used for?
Neisseria
–>Oxidase positive results in purple end product

What is indicated by a positive Indole test?
(+) for tryptophanase enzymatic activity on trytophan
–>positive result = endproduct indole reacts with kovacs reagent (yellow) forming red color
E. Coli

What test would one use to identify Proteus sp.?
Urease test
- urease enzymatic activity = hydrolysis of urea to ammonia which is indicated by pH change whereby the medium color goes from pale orange to pink

What is a test to confirm streptoccocus pneumonia?
Optochin Test - P disc
S.pneumoniae is optochin sensitive

What is the test used to differentiate group A streptococci from other streptococci?
Bacitracin susceptibility
“A disc” formation on blood agar

Know the picture of lactophenol cotton blue mount
Used to demonstrate fungal presence

Know picture of lactophenol cotton blue wet mount
Wet mount in vulvovaginal candidacies